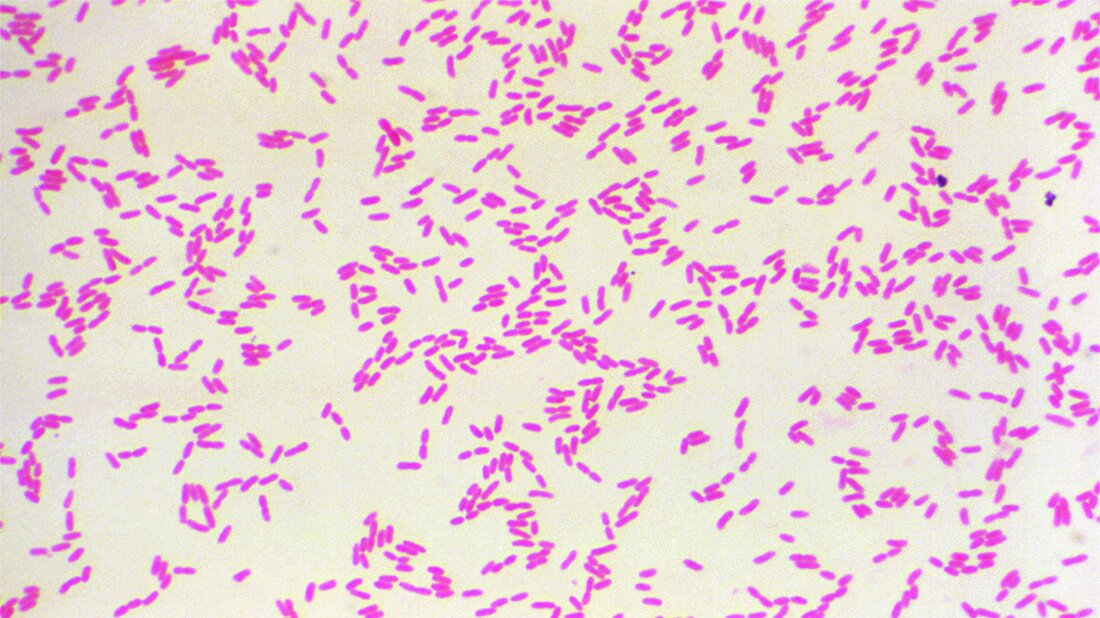
Burkholderia pseudomallei unter dem Mikroskop

Melioidose – „the great mimicker“
Zusammenfassung
Hierzulande ist die Melioidose eine typische Reiseerkrankung, die aus Endemiegebieten, insbesondere Nordaustralien und Südostasien, mitgebracht wird. Eine Infektion mit dem Erreger Burkholderia pseudomallei erfolgt über kleine Hautverletzungen oder dem Einatmen von Aerosolen. Die Diagnose gestaltet sich oft schwierig, da das Krankheitsbild anderen Erkrankungen ähnelt und die Labordiagnostik schwierig und in vielen Laboren nicht etabliert ist. Die Prognose der Erkrankten ist meist schlecht und viele Betroffene versterben trotz Antibiotika-Behandlung.
Schlüsselwörter: Melioidose, Burkholderia pseudomallei, Reiseerkrankung
Abstract
In Germany, melioidosis is a typical traveler’s disease that is brought from endemic areas, particularly northern Australia and south-east Asia. Infection with the pathogen Burkholderia pseudomallei usually occurs via small skin lesions or inhalation of aerosols. Diagnosis is often difficult as the clinical picture is similar to other diseases and laboratory diagnostics are difficult and not established in many laboratories. The prognosis for patients is frequently poor and many patients die despite antibiotic treatment.
Keywords: Melioidosis, Burkholderia pseudomallei, traveler’s disease
DOI: 10.53180/MTIMDIALOG.2025.0236
Entnommen aus MT im Dialog 4/2025
Dann nutzen Sie jetzt unser Probe-Abonnement mit 3 Ausgaben zum Kennenlernpreis von € 19,90.
Jetzt Abonnent werden